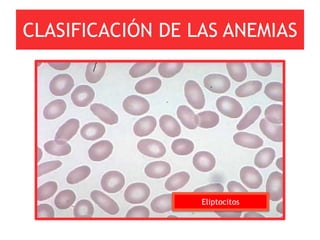
CLASIFICACIÓN DE LAS ANEMIAS




                  Eliptocitos
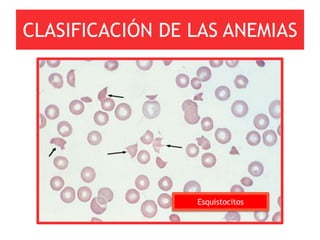
CLASIFICACIÓN DE LAS ANEMIAS




                 Esquistocitos

Este documento presenta una guía para el abordaje del paciente con anemia. Comienza definiendo la anemia y explicando la eritropoyesis y los reticulocitos. Luego describe la fisiopatología y clasificación de las anemias, enfocándose en el enfoque cinético y morfológico. Explica cómo clasificar las anemias de acuerdo al VCM en microcíticas, normocíticas y macrocíticas, y los pasos para diagnosticar las causas en cada categoría.